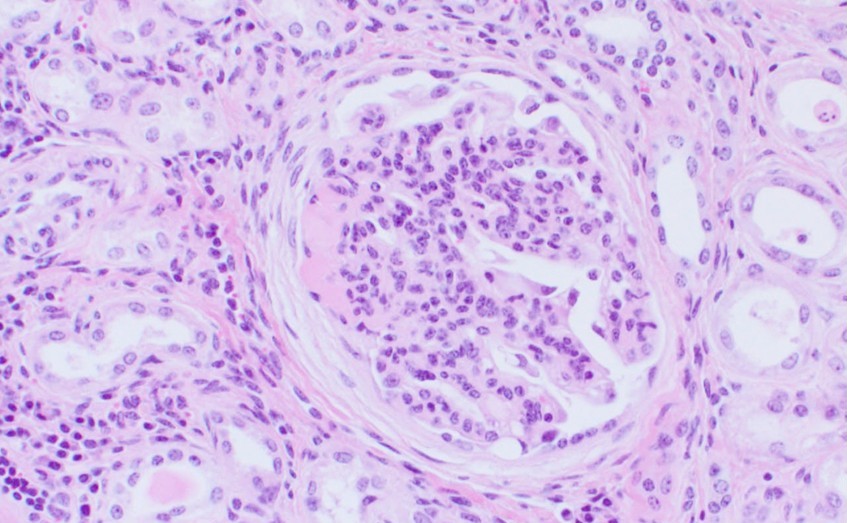

| 研究者名 | 古林 与志安 教授 |
|---|---|
| 所属 | グローバルアグロメディシン研究センター/獣医学研究部門 動物医療センター/診断検査科 獣医学教育国際認証推進室/室長 |
| 専門分野 | 獣医病理学、診断病理学 |
研究シーズ
- 2. 飢餓をゼロに
- 3. 全ての人に健康と福祉を
- 15. 陸の豊かさも守ろう
病理学的並びに分子病理学的手法を用いた疾患診断および病態解明
キーワード
病気・形態・病理・診断・疾患モデル
研究内容の特徴
帯広畜産大学が酪農・畜産地帯に位置することから、動物、特に産業動物の自然発生疾患に対する病理診断を日々行っています。その中から、新規あるいは稀有な病態を見出し、それら病態についての病理学的な研究を行うとともに、既知の病態の未解明の事象の解明に取り組んでいます。また、病理診断に分子生物学的手法を応用するための研究や、学内外の基礎・臨床研究分野の多くの先生と様々な共同研究も行っています。
技術アピール・マッチングニーズ
- 病理診断(病理解剖診断および病理組織診断)
- 病理診断のコンサルテーション
- 病理診断法・評価法の開発・確立
- 疾患モデルの病理学的解析
参考資料等